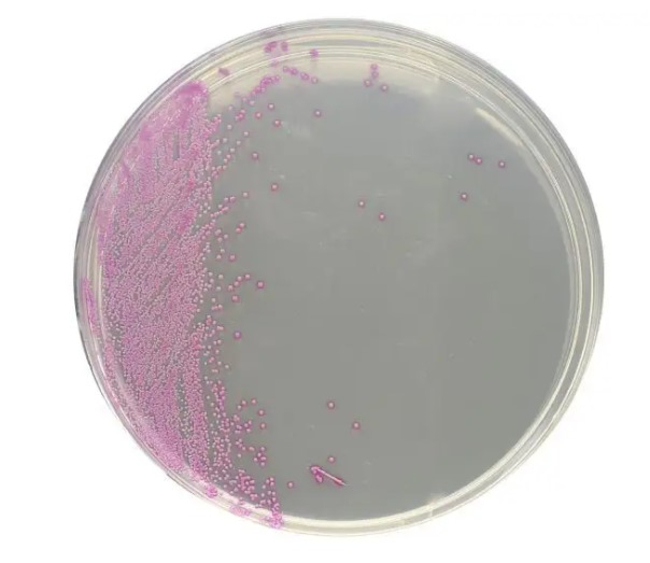

Search Fisher Scientific
Fisher Chemical
HardyCHROM™ Staphylococcus Aureus Chromogenic Medium
HardyCHROM™ Staph aureus is a chromogenic medium recommended for the isolation, differentiation, and enumeration of Staphylococcus aureus by colony color
Catalog number USFG311
Price (SGD)
76.00
Price (SGD)
76.00
- HardyCHROM™ Staph aureus allows for the rapid and reliable detection of S. aureus from both clinical and food specimens within 24 hours
- Selective agents inhibit the growth of gram-negative organisms, yeast, and some gram-positive cocci
Specifications
SpeciesStaphylococcus aureus, Staphylococcus species
AppearanceTranslucent
ColorLight Amber
Product TypeAgar Plate
Test TypeMicrobial Detection
Fill Volume18 mL
Incubation Conditions35°C
Incubation Time24 hr.
Unit Size